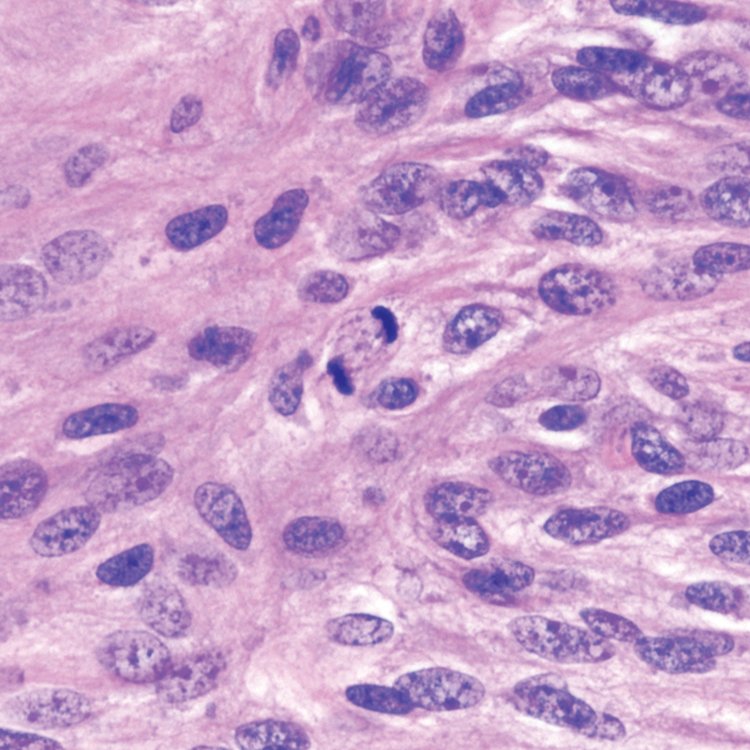
CraigHorbinski's tweet image. Gorgeous #anaphase #mitosis in a grade II #meningioma. You can even see the #microtubules in the mitotic spindle. 
Yeah, I'm the right profession! 🔬👍🏼
#pathology #neuropath #brain

#anaphase wyniki wyszukiwania
#Meta ...new name... So metaphase would going on ..then #anaphase then telo...then division...#finish #MarkZuckerberg #Metaverse #EmmaRose
A fantastic view of a cell with chromosomal instability: two bridges are better than one #mitosis #anaphase #chromosomalbridges

Gorgeous #anaphase #mitosis in a grade II #meningioma. You can even see the #microtubules in the mitotic spindle. Yeah, I'm the right profession! 🔬👍🏼 #pathology #neuropath #brain
Nouveau test @ducray.france 🥰 merci @theinsidersfrance ♥️ . #theinsiders #anaphase #ducray #ducrayfrance #shampooing #ducrayantichute #chutedecheveux #complementsalimentaires #anacaps #testsproduits #ambassadrice #soincheveux



Curious about who drives #anaphase? #spindle #mitosis #microtubules #MTmotors #kinesins #microscopy #ExM #STED #CRISPR #CellBiology disq.us/t/3k3odcv
Did we just see the #anaphase #spindle of a cell division in the opening ceremony of the #Tokyo2020 #Olympics? 😍

In @JCellBiol, Christopher Sorensen Turpin, Joshua Bembenek @BembenekLab et al. @WayneMedicine show that separase localization is precisely regulated to control chromosome segregation and exocytosis during #anaphase. hubs.la/Q02Yx1ZC0 #CellDivision

Infiltrating #Melanoma cells showing perfect #anaphase mitotic figures. 🔬🧬 #Melanoma #dermpath #dermpath #pathboards @PathSpotters

This guy knows his cell biology well literally 😎😎😎😁😁😁😍😍😍 Hope you get it dude @nakedcapsid #CellDivision #Anaphase #Prosphase #Metaphase #Telophase How about an algae tatoo for me haha no just kidding 😁😁😁
Have you seen this video before, @jstumpffVT? #tbt — When your grad school advisor gets a shoutout during a seminar, you must obtain photographic evidence. Yes, this is #anaphase but #metaphaseisstillthebestphase

🌀Look at that cover 🤩 It shows LUZP1 localisation in #anaphase. Learn more about how LUZP1 drives contractile ring dynamics in our latest #EditorsChoice by Hyodo et al. #WeekendReads, sorted: 🌀buff.ly/3P81uYe #CellBiology #Mitosis #Cytokinesis #OpenAccess

Serena et al @OxBiochNews reveal the molecular basis of MKLP2-dependent Aurora B transport from #chromatin to the #anaphase central #spindle during #mitosis: bit.ly/3bTZayt

Friday Biology PLC involves interpretive dance of the cell cycle #anaphase #STREAM @TabbynKnoe @LWiseBIO
Summer Showcase this evening with ex-pupil Harry Adams launching her debut album right here at EPA. One to watch for the future! Fabulous performances by our current musical pupils as well! Well done Mr Baldry and everyone involved! @MissOblivious_ #anaphase

$A token enthusiasts will love this meaning: Word: #anaphase Definition: the stage of meiosis or mitosis when chromosomes move toward opposite ends of the nuclear spindle #A_ARC20 #ARC20 #ATOMICALS
☕️Afonso et al. show that, during #anaphase, chromosome movement can be driven by large cytoplasmic flows. These dynein-dependent cytoplasmic flows scale with cell size, slowing in smaller cells, thereby scaling anaphase. bit.ly/4bpoMCU
$A token enthusiasts will love this meaning: Word: #anaphase Definition: the stage of meiosis or mitosis when chromosomes move toward opposite ends of the nuclear spindle #A_ARC20 #ARC20 #ATOMICALS
Christopher Sorensen Turpin, Joshua Bembenek @BembenekLab et al. @WayneMedicine show that separase localization is precisely regulated to control chromosome segregation and exocytosis during #anaphase. hubs.la/Q02YwYLs0 #CellDivision

In @JCellBiol, Christopher Sorensen Turpin, Joshua Bembenek @BembenekLab et al. @WayneMedicine show that separase localization is precisely regulated to control chromosome segregation and exocytosis during #anaphase. hubs.la/Q02Yx1ZC0 #CellDivision

#Dynein counteracts left-handed twist in the #anaphase spindle. From @LilaNeahring et al. @DumontLab @UCSF showing that torques within and outside the human spindle balance twist at anaphase. hubs.la/Q02BLbBx0 #Cytoskeleton #CellCycle #CellDivision #Mitosis

Torques within and outside the human spindle balance twist at #anaphase, say Lila Neahring @LilaNeahring, Sophie Dumont @DumontLab and colleagues @UCSF: hubs.la/Q02BKq410 #Cytoskeleton #CellCycle #CellDivision #Mitosis

La mitose est un processus de duplication cellulaire, dans lequel une cellule se divise en deux cellules filles génétiquement identiques. #prophase #métaphase #anaphase #télophase
🌀Look at that cover 🤩 It shows LUZP1 localisation in #anaphase. Learn more about how LUZP1 drives contractile ring dynamics in our latest #EditorsChoice by Hyodo et al. #WeekendReads, sorted: 🌀buff.ly/3P81uYe #CellBiology #Mitosis #Cytokinesis #OpenAccess


Dr Larrington's @SWSixthForm class prepared stained squashes of cells from garlic root tips to observe the stages of mitosis 🔬 #Metaphase #Anaphase #Biology


Ravie de pouvoir tester le shampoing et la lotion antichute de Ducray !!!! #sampleo #creastimreactiv #anaphase #ducray

🔥𝐀𝐧𝐚𝐩𝐡𝐚𝐬𝐞 𝐒𝐭𝐫𝐞𝐧𝐠𝐭𝐡𝐞𝐧𝐢𝐧𝐠 𝐂𝐨𝐧𝐝𝐢𝐭𝐢𝐨𝐧𝐞𝐫🔥 😎BENEFITS🥰 ✅FORTIFYING, VOLUMIZING AND DETANGLING ✅DESIGNED TO TREAT HAIR LOSS AND DEVITALIZED HAIR 🛒 𝗢𝗿𝗱𝗲𝗿 𝗡𝗼𝘄: 𝘄𝘄𝘄.𝗳𝗶𝘃𝗲𝗺𝗹.𝗰𝗼𝗺 #Anaphase #AnaphaseConditioner #conditioner #haircare

EDWARD SAYS: NOTHING, IT'S ANAPHASE. #TWILIGHT #ANAPHASE CHRISTIAN FROM FIFTY SHADES OF GREY, DARK, FREED SAYS: ANASTASIA STEELE #ANASTASIA
🌉 @MCB_Harvard researchers have found evidence that microscopic “inter-axis bridges,” which form between sister chromatids during #mitosis, play several crucial roles throughout #anaphase. 📌 bit.ly/3CGHLaQ

Now Playing Rinzen, Anaphase - Some Good Here rinzenmusic, #anaphase
#Meta ...new name... So metaphase would going on ..then #anaphase then telo...then division...#finish #MarkZuckerberg #Metaverse #EmmaRose
😍 Sorpresas chulas que te encuentras un miércoles por la mañana con sabor a lunes #anaphase #mitosis #phdlife

Christopher Sorensen Turpin, Joshua Bembenek @BembenekLab et al. @WayneMedicine show that separase localization is precisely regulated to control chromosome segregation and exocytosis during #anaphase. hubs.la/Q02YwYLs0 #CellDivision

During #anaphase, astral #microtubules & #dynein remove #myosin from the non-equatorial cell cortex & trigger a bidirectional cortical flow toward the equator, which facilitates assembly of the cytokinetic ring bit.ly/3cDlITE @midbody @SPOREMOHAN

#Microtubule and dynein-mediated removal of cortical myosin II promotes polar relaxation and facilitates assembly of the actomyosin contractile ring bit.ly/3cDlITE #cytokinesis #anaphase @SPOREMOHAN @midbody
Serena et al @OxBiochNews reveal the molecular basis of MKLP2-dependent Aurora B transport from #chromatin to the #anaphase central #spindle during #mitosis: bit.ly/3bTZayt

Serena et al. @OxBiochNews investigate how the #kinesin MKLP2 recognizes its cargo, the chromosome passenger complex, and promotes its transport away from #chromosomes in #anaphase bit.ly/3bTZayt

#SUMOylation stabilizes sister #kinetochore biorientation to allow timely #anaphase, say Xue Bessie Su, Adèle L. Marston @Marston_lab and colleagues. bit.ly/334jH0K #CellCycle #CellDivision

A fantastic view of a cell with chromosomal instability: two bridges are better than one #mitosis #anaphase #chromosomalbridges

#Dynein counteracts left-handed twist in the #anaphase spindle. From @LilaNeahring et al. @DumontLab @UCSF showing that torques within and outside the human spindle balance twist at anaphase. hubs.la/Q02BLbBx0 #Cytoskeleton #CellCycle #CellDivision #Mitosis

Torques within and outside the human spindle balance twist at #anaphase, say Lila Neahring @LilaNeahring, Sophie Dumont @DumontLab and colleagues @UCSF: hubs.la/Q02BKq410 #Cytoskeleton #CellCycle #CellDivision #Mitosis

Spotlight: Leeds and Asbury preview work from Henriques et al. (hubs.ly/Q03Zxskw0), which describes how #anaphase A and B are mechanically coordinated in #Celegans embryos. hubs.ly/Q03ZxqCz0 #Biophysics #CellDivision #Cytoskeleton #Development #Mitosis

Loss of two separate phosphohistone-dependent pools of Aurora B at #centromeres diminishes error correction efficiency and increases lagging #chromosomes in #anaphase, say Cai Liang, Fangwei Wang and colleagues bit.ly/34N0Wxe
Nouveau test @ducray.france 🥰 merci @theinsidersfrance ♥️ . #theinsiders #anaphase #ducray #ducrayfrance #shampooing #ducrayantichute #chutedecheveux #complementsalimentaires #anacaps #testsproduits #ambassadrice #soincheveux



Yang et al show that #Celegans CKS-1 is required, w/ CDK-1, for #anaphase B during oocyte #meiosis I; promotes anaphase onset thru. securin & cyclin B1 destruction in meiosis I & II, respectively; & acts positively w/ both securin & cyclin B3 in meiosis II hubs.la/Q03_WFhj0

#MsLoyaBio625 #Anaphase sister chromatids are pulled to opposite poles of the cell by the spindle fibers.

Model shows that WDR62 localizes KATNB1 at spindle poles to ensure synchronous #anaphase. From a study by Amanda Guerreiro, @divanova_1 @LabMeraldi @unige_en and colleagues. bit.ly/2UcCjue #Cellcycle #Celldivision #Cytoskeleton

Have you seen this video before, @jstumpffVT? #tbt — When your grad school advisor gets a shoutout during a seminar, you must obtain photographic evidence. Yes, this is #anaphase but #metaphaseisstillthebestphase

#Anaphase Red artist proof really popping on these black walls. #yesplease! #bandbeditions @BLKBX Trinity Leeds #florenceblanchard #screenprint

Something went wrong.
Something went wrong.
United States Trends
- 1. Joe Rogan N/A
- 2. #LetEmKnow N/A
- 3. #RSD2026 N/A
- 4. #ด้วงกับเธอตอนจบ N/A
- 5. DUANG WITH YOU FINAL EP N/A
- 6. Ibogaine N/A
- 7. Jarrett Allen N/A
- 8. Guatemala N/A
- 9. Mitoma N/A
- 10. #WrestleMania N/A
- 11. Scottie Barnes N/A
- 12. #Voices_for_SevEN N/A
- 13. Charles Dance N/A
- 14. NBA Playoffs N/A
- 15. Happy Birthday James N/A
- 16. Team 1 N/A
- 17. Chris Henry Jr. N/A
- 18. Julian Sayin N/A
- 19. Brighton N/A
- 20. Happy Anniversary N/A









































































